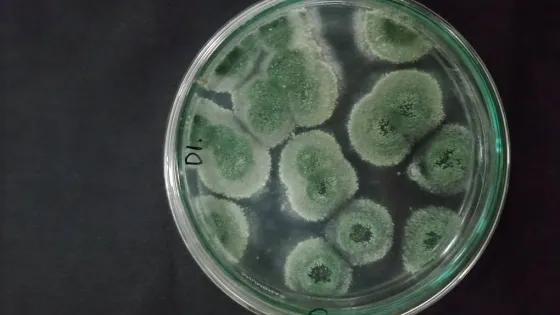
8549177

- Международный коллектив биотехнологов создал новый штамм грибков Metarhizium для приманивания комаров.
- Грибки вырабатывают цветочный аромат, который поможет замедлить распространение малярии и других болезней, переносимых комарами.
- Грибок абсолютно безопасен для человека, так как вещество лонгифолен активно используется в парфюмерии.
- Созданы специальные контейнеры для грибка, куда могут проникнуть только комары, но не другие насекомые.
- Химические пестициды и надкроватные сетки быстро теряют эффективность из-за развития устойчивости насекомых к ним.
- Грибки приманивают комаров с помощью цветочных ароматов, и добавление генов для производства лонгифолена усилило этот эффект.
- Ловушки с грибками уничтожали от 90% до 100% комаров в помещениях с источниками грибковых запахов, растений и людей.
- Подобные приманки могут стать безопасной заменой для пестицидов в тропиках и умеренных широтах.
Грибку - убийце комаров привили цветочный запах
24 окт 2025
Краткий пересказ
от нейросети YandexGPT
Источник:
nauka.tass.ru
Обложка: Изображение из статьи. Грибок из рода Metarhizium © Herselfta/Shutterstock/FOTODOM